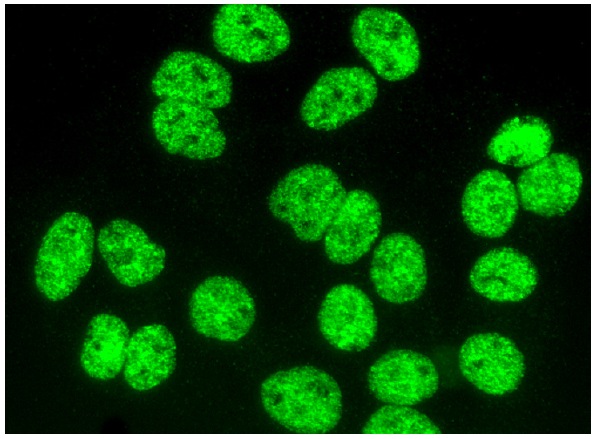
PPARγ2 Antibody (A-1) | SCBT - Santa Cruz Biotechnology

マイストア
変更
お店で受け取る
(送料無料)
配送する
納期目安:
2025.12.11 14:2頃のお届け予定です。
決済方法が、クレジット、代金引換の場合に限ります。その他の決済方法の場合はこちらをご確認ください。
※土・日・祝日の注文の場合や在庫状況によって、商品のお届けにお時間をいただく場合がございます。
プレミアムPPAP パスワード付きzip PPAP 問題について: NECセキュリティブログ | NECの詳細情報
パスワード付きzip PPAP 問題について: NECセキュリティブログ | NEC。Pedal Pilot Valve 9184276 Fits Hitachi Excavator ZAX200 ZX249。PPAPは何のため?その本質と有効なソリューション | Boxsquare。PPARγ2 Antibody (A-1) | SCBT - Santa Cruz Biotechnology。不具合なし綺麗な状態です10回ほどおしてます!自分は30年後プレミアムがつくとおもいます!。
ベストセラーランキングです
近くの売り場の商品
カスタマーレビュー
オススメ度 4.7点
現在、5357件のレビューが投稿されています。